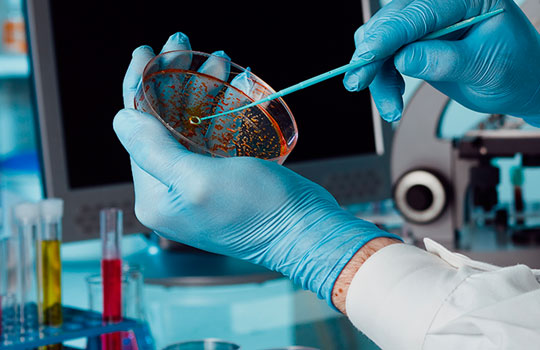

US MOLD HUNTERS offers their services in the Best Professional way possible.
We always strive to go above and beyond for every customer. This is our promise to you:
“WE WILL BE WITH YOU FROM THE
BEGINNING TO THE END AND AFTER!”
Mold Inspection and Testing
Your mold inspector will perform as many samples as necessary, depending on what is needed for your situation, to identify:
- Mold Problems
- The dimension of the Problem.
- Type of Mold
- The potential health problems associated with the type of mold.
Your certified mold inspector will complete a Mold Inspection.
- We look at all areas conducive to mold growth, not just the problem area.
- You will receive a report on this.
- If it is not obvious where moisture is coming from, we look for the moisture source during the inspection. It is imperative to fix the source before a remediation can take place.
- After the inspection is complete, your inspector will let you know what they have found and what type of testing is best for your situation. Together, you will decide if additional testing is necessary.
RESULTS: In 3 to 5 business days, you will receive your results.

Mold Remediation
If you need mold remediation, we will help you find a certified, mold remediation company that follows protocol. We provide this for our customers’ benefit only.
Clearance & Post Remediation Testing
Clearance is performed after the remediation work is done. The purpose is to ensure that the remediation was successful, thus the mold problem that existed before the work began is no longer a mold problem. After the remediation passes a posttest, you will receive a clearance letter (or non-clearance letter, if applicable). A clearance letter will assist you if you decide to sell your property in the future.

